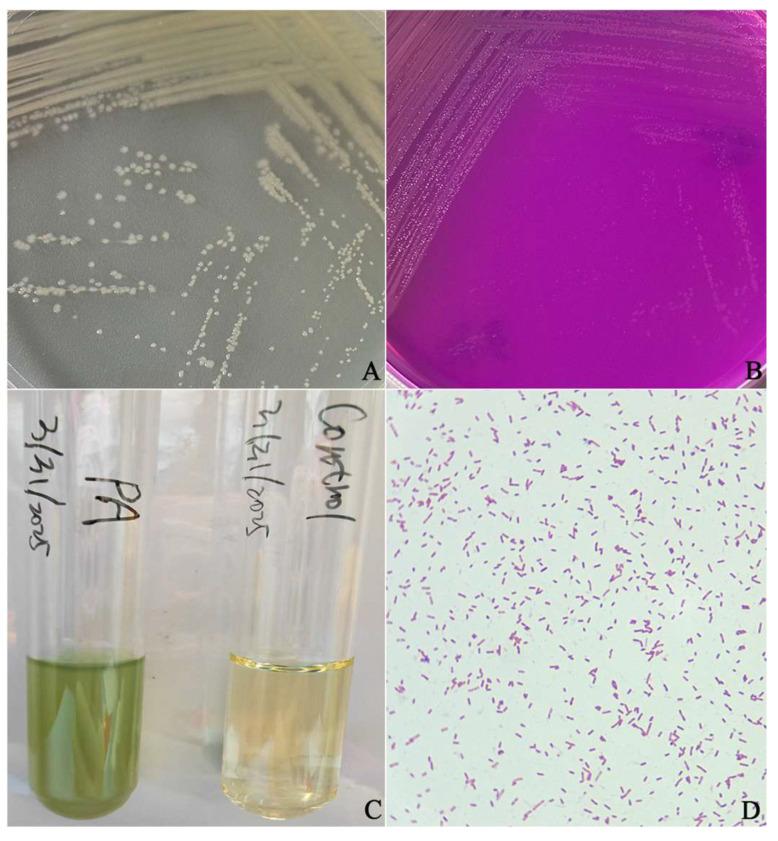
https://cdn.ncbi.nlm.nih.gov/pmc/blobs/0c46/12299744/7638cde590ff/vetsci-12-00636-g001.jpg

食蟹猴()的分离、鉴定及药敏试验
Isolation, Identification, and Drug Sensitivity Test of from Cynomolgus Monkey ().
作者信息
Li Heling, Qian Ziyao, Yan Yulin, Wang Hong
机构信息
State Key Laboratory of Primate Biomedical Research, Institute of Primate Translational Medicine, Kunming University of Science and Technology, Kunming 650500, China.
Yunnan Key Laboratory of Primate Biomedical Research, Kunming 650500, China.
出版信息
Vet Sci. 2025 Jul 3;12(7):636. doi: 10.3390/vetsci12070636.
In this study, we isolated and identified bacteria from the feces of a diarrheal cynomolgus monkey. The results showed that the isolated strain was , named PA/CM-101101. Morphological observations indicated that when cultured on Luria-Bertani (LB) nutrient agar at 37 °C for 24 h, the strain formed smooth, slightly elevated colonies with neat and wavy edges. On acetamide agar at the same temperature and duration, the colonies appeared flat with irregular edges and a faint pink periphery, while the medium changed to rose-red; in LB broth at 37 °C for 24 h, the medium became turbid and yellowish-green. Gram staining revealed that it was negative and rod-shaped, without sporulation characteristics. The 16S rRNA gene sequence analysis showed that the sequence identity of the strain shared more than 98.4% similarity with 11 strains of from various sources in GenBank. The animal toxicity test showed that it had a strong pathogenic effect on mice. The results of drug sensitivity tests showed that strain PA/CM-101101 was sensitive to amikacin, azithromycin, cefoperazone, ceftazidime, ceftriaxone, ciprofloxacin, gentamicin, imipenem, levofloxacin, meropenem, norfloxacin, ofloxacin, and polymyxin B; however, it displayed resistance to ampicillin, cefadroxil, cefazolin, erythromycin, and vancomycin. The research findings provide valuable insights for diagnosis and treatment strategies for cynomolgus monkeys. It also provides a reference for molecular epidemiological studies. To our knowledge, this is the first time isolated from the diarrhea feces of cynomolgus monkey has been reported.
在本研究中,我们从一只腹泻食蟹猴的粪便中分离并鉴定了细菌。结果显示,分离出的菌株命名为PA/CM - 101101。形态学观察表明,该菌株在37°C的Luria - Bertani(LB)营养琼脂上培养24小时后,形成光滑、稍凸起的菌落,边缘整齐且呈波浪状。在相同温度和培养时间的乙酰胺琼脂上,菌落扁平,边缘不规则,周边呈淡粉色,而培养基变为玫瑰红色;在37°C的LB肉汤中培养24小时后,培养基变浑浊并呈黄绿色。革兰氏染色显示其为阴性且呈杆状,无芽孢形成特征。16S rRNA基因序列分析表明,该菌株的序列与GenBank中来自不同来源的11株 的序列同一性相似度超过98.4%。动物毒性试验表明,它对小鼠有很强的致病作用。药敏试验结果显示,菌株PA/CM - 101101对阿米卡星、阿奇霉素、头孢哌酮、头孢他啶、头孢曲松、环丙沙星、庆大霉素、亚胺培南、左氧氟沙星、美罗培南、诺氟沙星、氧氟沙星和多粘菌素B敏感;然而,它对氨苄西林、头孢羟氨苄、头孢唑林、红霉素和万古霉素耐药。该研究结果为食蟹猴的诊断和治疗策略提供了有价值的见解。它也为分子流行病学研究提供了参考。据我们所知,这是首次报道从食蟹猴腹泻粪便中分离出的 。